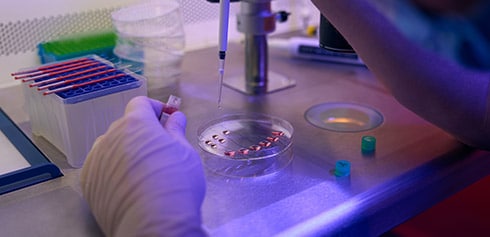

Qu’est-ce qu’un assistant en biotechnologie ?

L’assistant en biotechnologie est un acteur incontournable des laboratoires de recherche et des industries biotechnologiques. Son quotidien ? Manipuler des échantillons biologiques, effectuer des analyses, et contribuer au développement de produits innovants dans des secteurs variés comme la santé, l’agroalimentaire ou l’environnement.
Mais rassure-toi, ce métier ne rime pas qu’avec des pipettes et des gants en latex ! C’est aussi une aventure humaine et scientifique qui te permettra de collaborer avec des équipes passionnées et de participer à des projets d’envergure. Tu as toujours rêvé de te sentir comme un Sherlock Holmes de la biologie ? Bingo, ce job est fait pour toi !
Les missions d’un assistant en biotechnologie
Réaliser des tests et analyses biologiques ou chimiques.
Contrôler la qualité des produits selon les protocoles définis.
Participer au développement et à l’amélioration de procédés biotechnologiques.
Gérer les équipements de laboratoire et garantir leur bon fonctionnement.
En clair, tu seras le héros de l’ombre, veillant à ce que chaque étape de la recherche ou de la production soit réalisée dans les règles de l’art. Et entre nous, qui ne voudrait pas sauver le monde un échantillon à la fois ?

Les compétences nécessaires pour briller en tant qu’assistant en biotechnologie

Pour exceller dans ce métier, il te faudra :
Un goût pour le travail en équipe et la communication (même pour discuter des aventures de tes pipettes préférées).
Un solide sens de l’organisation.
Une grande rigueur scientifique (oui, même les lignes Excel doivent te respecter).
Des connaissances pointues en biologie, chimie et technologies associées.
Comment devenir assistant en biotechnologie ?
Le chemin pour arriver à ce métier peut être direct ou sinueux, mais dans tous les cas, il passe par des formations spécifiques. Voici un petit tour d’horizon des parcours possibles grâce à AFI24 :
Les bases : les formations BAC+2
Pour poser les premières briques de ton avenir, les formations de niveau BAC+2 te fourniront les bases scientifiques indispensables. Cependant, elles ne suffiront pas pour accéder directement au métier d’assistant en biotechnologie. Eh oui, il te faudra aller plus loin pour devenir le Jedi des biotechnologies !
Quelques exemples de formations :
- BTS Bio Analyses et Contrôles à l’ETSL: une formation idéale pour acquérir des compétences en analyses biologiques et chimiques.
- BTS Métiers de la Chimie (disponible notamment à l’ENCPB (75), à l’ETSL (75) – au Lycée Galilée (75) ou au Lycée Notre Dame (28), au Lycée Paul Constans (03) ou encore au Lycée Gustave Eiffel (59)) : pour se familiariser avec les techniques de laboratoire et la chimie appliquée.
- BTS Métiers de l’Eau (ENCPB) : pour explorer les procédés environnementaux liés aux biotechnologies.
- BTS Métiers de la Mesure (ENCPB (75), Lycée Gustave Eiffel (59)) : pour apprendre à utiliser des équipements d’analyse avancés.
Tu lis cet article entre décembre et mars ? tu as formulé tous tes vœux parcoursup ? Avec l’apprentissage tout est encore possible !
Découvre toutes les étapes clés du calendrier Parcoursup
Les formations BAC+3 : la spécialisation
Avec un niveau Licence Professionnelle, tu pourras te spécialiser et te préparer directement aux exigences du poste d’assistant en biotechnologie.
Formations proposées par nos partenaires :
- Licence Pro Biotechnologie (Université Paris Cité – Santé) : une formation taillée pour développer des compétences en manipulation d’échantillons biologiques et en gestion de projets biotechnologiques.
- Licence Pro Contrôle et Développement Analytique (Université Paris Cité – Santé) : un focus sur les techniques d’analyse et de contrôle qualité.
- Licence Pro Génomique (CNAM) : pour une spécialisation pointue sur l’ADN et les analyses génétiques.
- Licence Pro Qualité, Hygiène, Santé, Sécurité, Environnement (IUT de Béthune) : pour maîtriser les normes de qualité et de sécurité dans les biotechnologies.
Niveau BAC+5 : atteindre l’excellence
Pour te donner une longueur d’avance, pourquoi ne pas viser un Master ? Ce niveau te permettra d’accéder à des postes avec davantage de responsabilités. En gros, tu passes du statut de Padawan à celui de Maître Jedi des biotech.
Quelques exemples :
- Master Chimie et Sciences des Matériaux à l’Université d’Évry et MASTER Sciences et Génie des Matériaux à l’Université de Tours : idéal pour explorer les aspects avancés de la biotechnologie et des matériaux.
- Master Chimie Contrôle et Qualité (CY Tech) : une formation pointue pour ceux qui souhaitent maîtriser les normes et procédures de contrôle.
- Master Risques et Environnement (UPEC) : pour développer des compétences en gestion durable et environnementale des biotechnologies. Cependant, son orientation managériale et axée sur les collectivités le rend moins adapté aux missions techniques et de laboratoire propres au métier d’assistant en biotechnologie.
Et si la cosmétique était ton domaine de prédilection ?
Le domaine cosmétique offre d’énormes opportunités aux assistants en biotechnologie. Tu pourras contribuer au développement de produits innovants comme des crèmes, des soins capillaires ou des maquillages intégrant des actifs biologiques ou biotechnologiques. Ce secteur en plein essor mise sur la recherche et l’innovation pour répondre aux attentes des consommateurs.
Formations idéales pour accéder au secteur cosmétique :
- BTS Métiers de la Chimie (disponible notamment à l’ENCPB (75), à l’ETSL (75) – au Lycée Galilée (75) ou au Lycée Notre Dame (28), au Lycée Paul Constans (03) ou encore au Lycée Gustave Eiffel (59) ) : parfait pour travailler sur la formulation des produits cosmiques.
- Licence Pro Chimie Formulation (Sorbonne) : indispensable pour apprendre les techniques de formulation et d’analyse des produits.
- Master Chimie Contrôle et Qualité (CY Tech) : pour garantir que les produits respectent les normes de qualité et de sécurité.
Et l’apprentissage dans tout ça ?
En choisissant une formation par apprentissage avec AFI24, tu accèdes à une expérience unique qui combine l’acquisition de compétences théoriques et pratiques. Non seulement tu développes une expertise technique, mais tu acquiers également une précieuse expérience professionnelle directement sur le terrain.
Avec AFI24, tu n’es jamais seul. Notre équipe t’accompagne pas à pas tout au long de ton parcours, que ce soit pour choisir la formation idéale, trouver ton entreprise d’accueil, ou encore optimiser ton expérience d’apprentissage. C’est un peu comme si tu étais un padawan de la gestion de l’innovation chimique : tu apprends aux côtés des meilleurs, tout en préparant ton avenir professionnel.
Et puis, l’apprentissage, c’est aussi être rémunéré pour ses études. Avoue, ça ne serait pas désagréable de recevoir un salaire tout en étudiant, non ?
C’est également une occasion en or pour tisser ton réseau professionnel et ouvrir la porte à de nombreuses opportunités d’emploi en tant que futur expert de l’innovation chimique.
Alors, prêt à révolutionner le monde de la chimie une innovation à la fois ? Rejoins dès maintenant une de nos formations et deviens le héros que les industries attendent !
Les débouchés : et après ?
Une fois ton diplôme en poche, tu pourras travailler dans :
- Les laboratoires pharmaceutiques.
- Les entreprises d’agroalimentaire.
- Les structures de recherche publique ou privée.
- Les industries cosmétiques, un secteur en plein essor où tes compétences seront très recherchées.
Et si tu veux aller encore plus loin, tu pourras toujours te former à de nouveaux métiers ou évoluer vers des postes de chef de projet ou d’ingénieur.
Ça y est ? Prêt à te lancer dans une carrière palpitante et utile ? L’assistant en biotechnologie est un métier d’avenir, et AFI24 est là pour t’accompagner sur la route du succès. N’hésite pas à explorer toutes nos formations et à trouver celle qui te correspond. Allez, hop, direction www.afi24.org !







